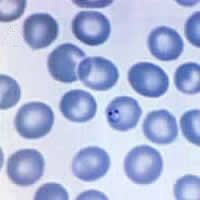
Case 36 ImageA
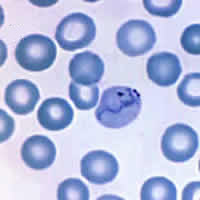
Case 36 Image B
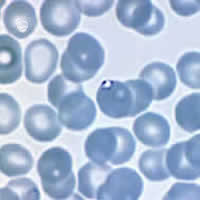
Case 36 Image C
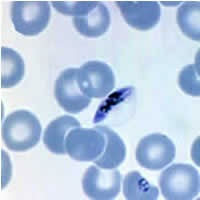
Case 36 Image D
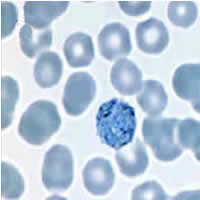
Case 36 Image E
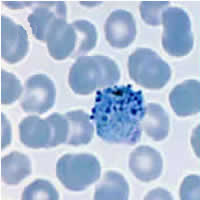
Case 36 Image F
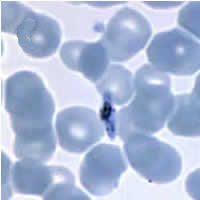
Case 36 Image G

|
|
[Last Modified: ] |
Case
35
A parasitologist from CDC was assigned to a primate research facility
in Kenya to teach a course entitled “An Introduction to Laboratory Methods
for the Diagnosis of Parasitic Diseases.” Ten staff members at the
research facility volunteered to collect stool specimens for demonstration
purposes in the class. Their specimens were preserved in 10% formalin
and used to demonstrate the formalin-ethyl acetate concentration procedure.
None of the staff members had health complaints at the time of collection.
The following images show what was seen in one of the specimens
(Figures A through H). What is your diagnosis?
Based on what criteria?
 |
| A |
 |
| B |
 |
 |
| C | D |
 |
 |
| E | F |
 |
 |
| G | H |
Click here for the answer to Case 35.
Case
36
A 24-year-old thrill seeker from Montana went on a three week Central American
excursion to Guatemala, Honduras, Nicaragua, and Panama. He traveled as much as possible on his trail bicycle. Though recommended,
he did not take malaria prophylaxis. Two days before his return
to the United States, he developed a low-grade fever. The next day
his fever was accompanied by chills and muscle aches. After arriving
home, he went to the hospital emergency room at the request of his mother. A thin blood smear was made and stained
with Giemsa. The following images show the objects seen in his blood
smears (Figures A through G). What is your diagnosis?
Based on what criteria?
|
|
| A | B |
|
|
| C | D |
|
|
| E | F |
|
| G |
Click here for the answer to Case 36.
|
|||